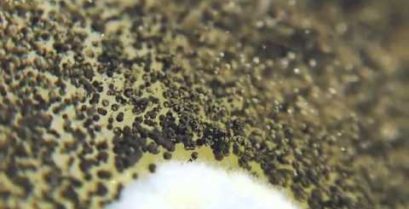

Najveći smaragd na svetu
Овај џиновски смарагд тежак је 11 килограма и процењује се да вреди око милион долара. Exorychtike u Brazilu i je najveći do sada pronađeni.
Zli plan od soma
Koja majka štiti svoje mladunce imajući u usta. Ali som da pripremi pakostan protiv plana.
Planinski biciklizam u šumi
Divan predeo otoka Vancouver, i planinski biciklizam sa biciklista Strahan Loken
Najspektakularnija video klipovi
Novi video klip od u redu idi na stazi 'potrebna/prvi ' je jednostavno je preterana proizvodnja. Sa puno mašte i rad, το τετραμελές συγκρότημα από το Σικάγο έφτιαξε χωρίς ψηφιακά εφέ το πιο θεαματικό βιντεοκλίπ που έχουμε [...]
Paraliza
Paraliza u snu je čudnog fenomena u kojoj žrtva kad se on probudi ne možete premestiti ili govori, και σε πολλές [...]
Skokovi na Aljasci
Na temperaturama iznad najhladniju tačku, Hurdman je Andy čini skokovi u vodama ostrvo glecer, na Aljasci
Gljivice pod mikroskopom
Rast od različitih vrsta gljiva koje rastu, u timelapse koji je video. Uključene gljivice aspergillus, фумигатус, ботритис, муцор, trichoderma i cladosporium.
Je li neko za bilijar?
Kolekcija impresivna trikove u bilijarski stol iz StuntsAmazing tima
Pas koji hoda na dve noge
Ovaj pas je rođen bez dva prednje noge zbog genetske deformacije. Tako da od malih nogu, on je naučio da hoda uspravno.
Dobri ljudi æe
Na kolovozu u Rusiji, ntelaparei vodič sa njegov auto pored puta. Nakon nekoliko minuta gomila prolazna upravljački programi prestati da pomogne.



 (3)
(3)